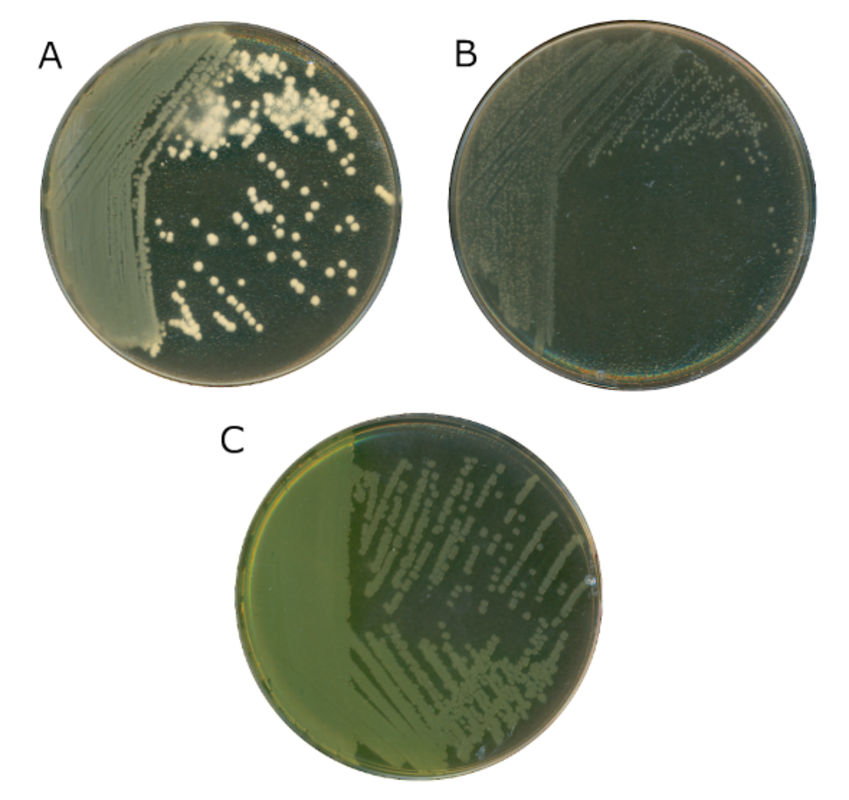
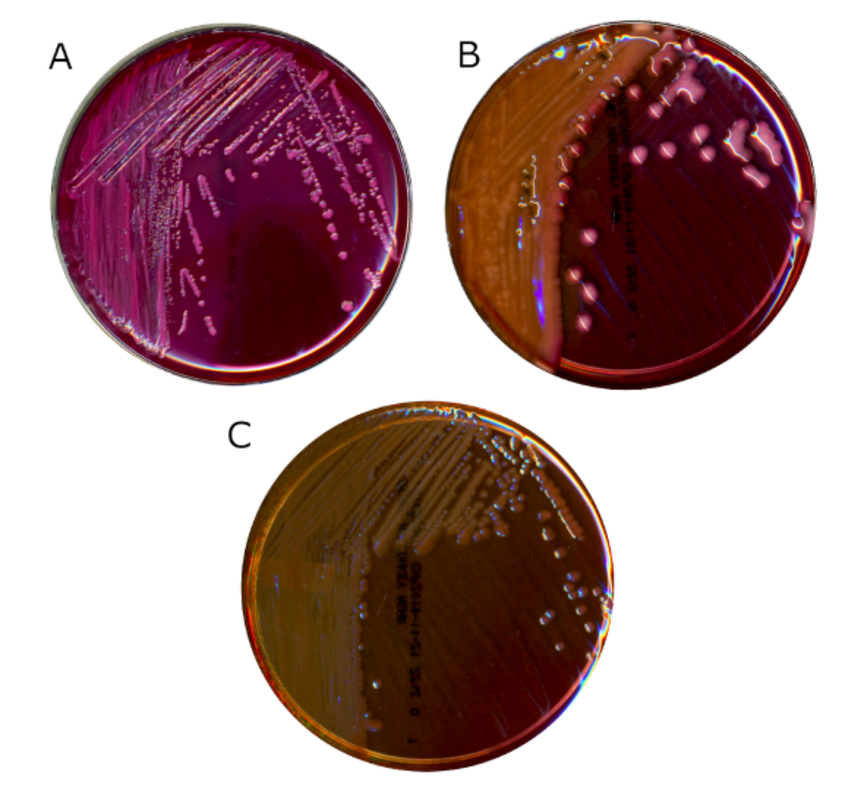

В конце 1890-х годов Альфред МакКонки работал в Ливерпульском университете под эгидой Королевской комиссии по очистке сточных вод.
Этой группе было поручено защитить население от заболеваний, передающихся через воду, путем разработки передовых методов очистки сточных вод. Чтобы оценить эффективность различных режимов очистки сточных вод, комиссия обязательно должна была определить, остается ли очищенная вода загрязненной фекалиями.
Часть работы МакКонки в комиссии заключалась в исследовании источников питьевой воды на наличие грамотрицательных энтеральных организмов. Эти бактерии являются нормальными обитателями желудочно-кишечного тракта человека, а также встречаются у других млекопитающих, рептилий и птиц. Хотя сами они не всегда вызывают заболевания, их присутствие является индикатором фекальной контаминации и, следовательно, потенциального присутствия других патогенов, передающихся с фекалиями.
Для идентификации энтеральных организмов образцы воды высевали на твердые среды, а образовавшиеся колонии подсчитывали и идентифицировали. Однако усилия МакКонки не были успешными из-за того, что каждый миллилитр очищенной воды мог по-прежнему содержать сотни или тысячи бактерий. Многие из этих организмов, которые МакКонки называл "обычными земными организмами", не предсказывали загрязнения. Неудивительно, что в его образцах часто вырастало большое количество колоний на стандартных питательных средах. Несмотря на разбавление, оказалось трудно идентифицировать энтеральные микроорганизмы, которые могли там присутствовать.
Поэтому МакКонки нужен был способ ограничить этот фон флоры окружающей среды и позволить расти только интересующим его бактериям. Среды, которые могут выполнять эту функцию, сегодня известны как селективные среды. Его стратегия отбора энтеральных организмов заключалась в добавлении желчных кислот в стандартную среду. Желчные кислоты - это амфипатические молекулы, обнаруженные в кишечнике, которые помогают пищеварению, эмульгируя жиры и позволяя им транспортироваться в водной среде.
Клеточные мембраны также очень похожи на жировые, поэтому желчные кислоты токсичны для многих организмов из-за способности нарушать этот барьер. Энтеральные организмы, однако, должны выдерживать постоянную атаку желчных кислот в кишечнике и поэтому выработали механизмы сопротивления их действию. Поэтому энтерики (и некоторые другие грамотрицательные бактерии, в частности, Pseudomonas) проходят отбор на средах, содержащих желчь.
Помимо обогащения для грамотрицательных бактерий, МакКонки также хотел иметь возможность различать типы энтеральных организмов. Особый интерес представляло определение того, является ли колония Escherichia coli (тогда Bacillus coli communis) или Salmonella enterica serovar Typhi (тогда B. typhi abdominalis). Хотя для окончательной идентификации этих организмов требовались дополнительные исследования, Макконки использовал предыдущее наблюдение Теодора Эшериха (в честь которого назван род Escherichia) о том, что E. coli ферментирует лактозу, тогда как Salmonella не ферментирует лактозу, чтобы быстро исключить или не исключить эти организмы на глаз.
Эта среда была изготовлена с использованием современных компонентов бактериологических сред в соответствии с оригинальной рецептурой Макконки, опубликованной в журнале The Lancet в 1900 году. Чистая дезоксихолевая кислота заменила смесь гликолевой кислоты и таурохолевой кислоты, первоначально используемую МакКонки. На фото А показана Escherichia coli, ферментирующая лактозу. Белый цвет вокруг колонии представляет собой осадок желчи. На фото Б показана Klebsiella pneumoniae. Хотя этот организм также ферментирует лактозу, он не производит достаточно кислоты для осаждения желчи и на этой среде выглядит как неферментирующий. На фото С показана Pseudomonas aeruginosa, неферментирующая лактозу. Источник: K.P. Smith.
Когда бактерии ферментируют сахар, pH среды становится кислым. Конечно, кислотность нельзя наблюдать напрямую, поэтому ферментация сахаров традиционно оценивалась в бульонных средах, содержащих химический индикатор pH (часто лакмус). Однако если бульонные среды содержали более одного организма, как это часто случалось с образцами воды Макконки, любые ферментирующие бактерии понижали рН и скрывали присутствие неферментирующих организмов. Макконки нужен был способ оценки ферментации лактозы на отдельных колониях на твердой среде. Для этого он ввел лактозу непосредственно в агар. Изменения pH, связанные с ферментацией, наблюдались с учетом того, что желчные кислоты выпадают в осадок в кислой среде. Таким образом, колонии, ферментирующие лактозу, были окружены дымкой осажденной желчи.
После того, как первое описание агара МакКонки было опубликовано в журнале The Lancet в 1900 году, эта среда стала быстро использоваться теми, кто интересовался микробиологией воды. Однако другие ученые признали, что оригинальный рецепт Макконки имел некоторые ограничения. Одним из них была сложность оценки ферментации лактозы в организмах, которые в процессе ферментации не вырабатывали достаточно кислоты для осаждения желчи. Чтобы решить эту проблему, Альберт Грюнбаум и Эдвард Хьюм добавили нейтральный красный, индикатор рН, который переходит от желтого цвета при основном рН к красному при кислом или нейтральном рН. Это добавление позволило повысить чувствительность обнаружения ферментации лактозы.
Еще одним ограничением было то, что желчь была единственным селективным агентом, что позволяло расти грамположительным организмам, устойчивым к желчи. Модификация Грюнбаума и Хьюма дополнительно содержала кристаллический фиолетовый, краситель, который, как ранее показали Вильгельм фон Дригальски и Генрих Конради, ингибирует грамположительные микроорганизмы. Это добавление было важно для повышения селективности, чтобы исключить Enterococcus spp.
К 1930 году в справочнике микробиологических сред было опубликовано 10 модификаций агара МакКонки. Они включали вариации содержания желчи, замену лактозы другими сахарами, изменение показателя pH или добавление неорганических солей. Среди всех этих вариантов именно формула Грюнбаума и Хьюма выдержала испытание временем и является (с небольшими изменениями) основой современного агара МакКонки.
Современный, коммерчески доступный агар МакКонки. На фото А показана Escherichia coli, ферментирующая лактозу. Обратите внимание на непрозрачный розовый желчный осадок вокруг колоний. На фото Б показана Klebsiella pneumoniae, также ферментирующая лактозу. Колонии розовые, что указывает на выработку кислоты, но желчный осадок отсутствует. На фото С показана Pseudomonas aeruginosa, неферментирующая лактозу. Источник: K.P. Smith.
Почти 120 лет спустя агар МакКонки по-прежнему широко распространен в клинических лабораториях, где он регулярно используется для выделения неспорообразующих грамотрицательных организмов из культур ран, мочи, кала и крови. Кроме того, он как важный инструмент для тестирования качества воды. Несмотря на фундаментальные изменения в микробиологической практике, включая автоматизацию, молекулярную генетику и масс-спектрометрию, представляется невероятным, что среда МакКонки по-прежнему будет использоваться в обозримом будущем.
